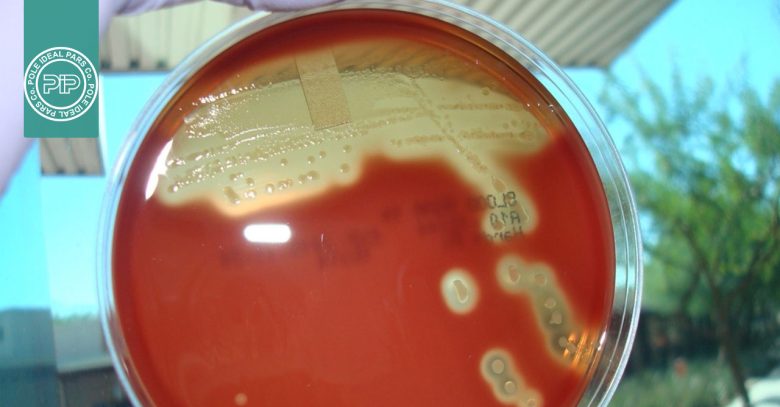
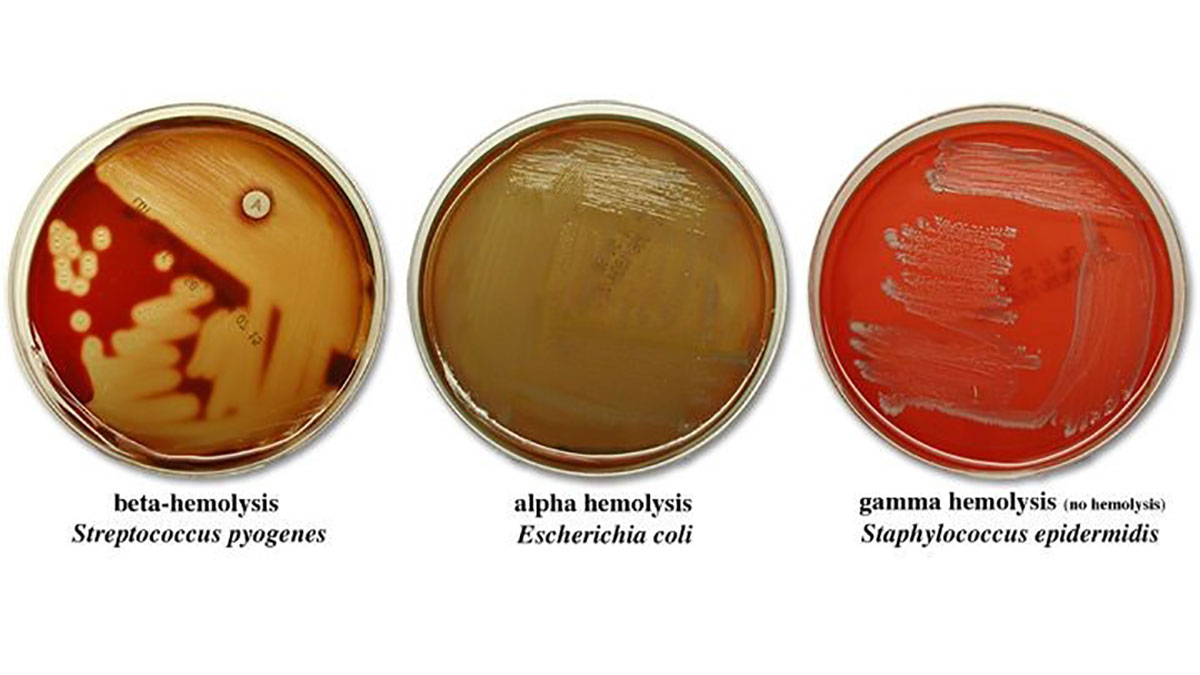
همولیز استرپتوکوک

همولیز استرپتوکوک ها ، راهنمای جامع انواع همولیز و کاربردهای تشخیصی
همولیز استرپتوکوک ها یکی از بنیادیترین مفاهیم در میکروبیولوژی پزشکی و تشخیص آزمایشگاهی محسوب میشود. جنسStreptococcus شامل گروهی ناهمگون از باکتریهای گرممثبت است که در اشکال کروی دیده میشوند و به دلیل جدایی ناقص سلولها پس از تقسیم، معمولاً بهصورت زنجیرهای در زیر میکروسکوپ مشاهده میگردند.
برخی گونهها بهعنوان فلور طبیعی بدن انسان و حیوانات شناخته میشوند، در حالی که گونههای دیگر میتوانند عامل طیف گستردهای از بیماریها، از عفونتهای خفیف دستگاه تنفسی فوقانی گرفته تا بیماریهای شدید و تهدیدکننده حیات باشند. در ادامه این مقاله قصد داری به بررسی همولیز استرپتوکوک ها و انواع آن بپردازیم. پس در ادامه با ما همراه باشید.
استرپتوکوکها و اهمیت آنها در پزشکی و تشخیص آزمایشگاهی

استرپتوکوکها گروهی متنوع از باکتریهای گرممثبت هستند که بهصورت کوکسیهای زنجیرهای دیده میشوند و نقش مهمی در میکروبیولوژی پزشکی دارند. بسیاری از گونههای این باکتریها بهطور طبیعی در بدن انسان، بهویژه در دهان، حلق و دستگاه گوارش حضور دارند، اما در شرایط خاص میتوانند به عوامل بیماریزا تبدیل شوند. در این میان، بررسی همولیز استرپتوکوک یکی از نخستین و مهمترین روشها برای شناخت رفتار زیستی و پاتوژنیک این باکتریها محسوب میشود.
استرپتوکوکها قادرند طیف گستردهای از بیماریها، از عفونتهای خفیف مانند گلودرد تا بیماریهای شدیدتری مانند پنومونی، مننژیت و سپسیس ایجاد کنند. تفاوت در توانایی ایجاد همولیز، که در قالب همولیز استرپتوکوک ها روی محیط بلاد آگار مشاهده میشود، ارتباط نزدیکی با شدت بیماری و اهمیت بالینی هر گونه دارد و به افتراق گونههای مختلف کمک میکند.
از نظر تشخیص آزمایشگاهی، همولیز استرپتوکوکها همچنان یک شاخص ساده، سریع و بسیار ارزشمند است. مشاهده الگوی همولیتیک روی بلاد آگار، در کنار سایر تستهای تشخیصی، مسیر شناسایی دقیق باکتری و تصمیمگیری درمانی مناسب را هموار میسازد و به همین دلیل جایگاه ویژهای در آموزش و عمل بالینی دارد.
تعریف همولیز و اهمیت آن در استرپتوکوک ها
همولیز به فرآیند تخریب یا تغییر ساختاری گلبولهای قرمز خون (Red Blood Cells) اطلاق میشود که در اثر ترشح سموم و آنزیمهایی به نام همولیزین توسط باکتری رخ میدهد. این فرآیند بهطور کلاسیک روی محیط کشت بلاد آگار بررسی میشود.
محیط بلاد آگار به دلیل دارا بودن گلبولهای قرمز، امکان مشاهده مستقیم اثرات همولیتیک باکتری را فراهم میکند و به همین دلیل نقش محوری در شناسایی اولیه همولیز استرپتوکوک ها دارد.
تکامل تاریخی طبقهبندی همولیز استرپتوکوک ها

در اوایل قرن بیستم، دانشمندان دریافتند که الگوی تخریب گلبولهای قرمز میتواند بهعنوان یک معیار افتراقی مهم برای استرپتوکوک ها مورد استفاده قرار گیرد.
در سال 1919، Brown سه اصطلاح آلفا، بتا و گاما را برای توصیف الگوهای همولیتیک معرفی کرد. این طبقهبندی بعدها با سیستم Lancefield grouping تکمیل شد که بر اساس پلیساکاریدهای دیواره سلولی باکتری انجام میشود.
تا کنون بیش از ۱۳ گروه سرولوژیک شناسایی شده است که از میان آنها گروههای A، B، C، G، Streptococcus pneumoniae و گروه ویریدانس بیشترین اهمیت بالینی را در بحث همولیز استرپتوکوک ها دارند.
انواع همولیز استرپتوکوک ها و ویژگیهای تشخیصی آنها
در ادامه به بررسی انواع همولیز در استرپتوکوک ها خواهیم پرداخت.
همولیز استرپتوکوک ها نوع بتا | تخریب کامل گلبولهای قرمز
در همولیز استرپتوکوک ها از نوع بتا، گلبولهای قرمز اطراف کلنی باکتری بهطور کامل تخریب میشوند. نتیجه این فرآیند، ایجاد یک ناحیه کاملاً شفاف و روشن در اطراف کلنی است که نشاندهنده لیز کامل هموگلوبین میباشد.
این نوع همولیز معمولاً ناشی از ترشح دو همولیزین اصلی است:
- همولیزین O: حساس به اکسیژن و در شرایط هوازی غیرفعال
- همولیزین S: پایدار در برابر اکسیژن و دارای اثر سیتوتوکسیک قوی
به همین دلیل، شدت همولیز استرپتوکوک ها نوع بتا در شرایط بیهوازی یا کماکسیژن بیشتر دیده میشود.
نمونههای بالینی مهم در همولیز استرپتوکوک ها نوع بتا
- Streptococcus pyogenes گروه A عامل فارنژیت چرکی، تب روماتیسمی و گلومرولونفریت
- Streptococcus agalactiae گروه B عامل مهم عفونتهای نوزادی، سپسیس و مننژیت
همولیز استرپتوکوک ها نوع آلفا | همولیز ناقص و تغییر رنگ
در همولیز استرپتوکوک ها از نوع آلفا، تخریب کامل گلبول قرمز رخ نمیدهد. بهجای آن، یک ناحیه سبز یا سبز–قهوهای در اطراف کلنی دیده میشود. این تغییر رنگ به دلیل اکسیداسیون آهن موجود در هموگلوبین و تشکیل متهموگلوبین است.
از نظر میکروسکوپی، غشای گلبول قرمز سالم باقی میماند؛ بنابراین، این نوع واکنش همولیز واقعی محسوب نمیشود، بلکه یک تغییر شیمیایی در هموگلوبین است.
نمونههای مهم در همولیز استرپتوکوک ها نوع آلفا
- Streptococcus pneumoniae: عامل اصلی پنومونی لوبار، مننژیت و اوتیت مدیا
- استرپتوکوکهای ویریدانس: از عوامل شایع اندوکاردیت تحتحاد
در همولیز استرپتوکوک ها، هرگونه رنگ سبز یا قهوهای در اطراف کلنی—پس از انکوباسیون طولانی—بهعنوان همولیز آلفا در نظر گرفته میشود و نباید با همولیز بتای ضعیف اشتباه شود.
همولیز استرپتوکوک ها نوع گاما | عدم تخریب گلبولهای قرمز
در همولیز استرپتوکوک ها از نوع گاما، هیچگونه تغییر مشخصی در گلبولهای قرمز اطراف کلنی مشاهده نمیشود. نه ناحیه شفاف بتا وجود دارد و نه تغییر رنگ سبز آلفا
.گاهی محیط کشت بهطور خفیف قهوهای میشود که این پدیده به شرایط انکوباسیون مربوط است و نشاندهنده همولیز واقعی نیست.
نمونههای مهم در همولیز استرپتوکوک ها نوع گاما
- Enterococcus faecalis
- Enterococcus faecium
این باکتریها از عوامل مهم عفونتهای بیمارستانی، عفونتهای ادراری و اندوکاردیت هستند.
تست CAMP و نقش آن در همولیز استرپتوکوک ها
در همولیز استرپتوکوک ها، پدیده همافزایی همولیتیک اهمیت ویژهای دارد. Streptococcus agalactiae بهتنهایی همولیز بتای ضعیفی ایجاد میکند، اما در کنار گونههای خاصی از Staphylococcus aureus، واکنش همولیتیک بسیار قویتری مشاهده میشود.
این واکنش اساس تست CAMP است که یکی از تستهای کلاسیک و معتبر برای شناسایی استرپتوکوکهای گروه B محسوب میشود.
نقش حیاتی همولیز استرپتوکوک ها در آزمایشگاه
همولیز استرپتوکوک ها همچنان یکی از پایهایترین ابزارهای تشخیصی در میکروبیولوژی پزشکی است. تشخیص صحیح الگوی همولیتیک به آزمایشگاهها کمک میکند تا مسیر شناسایی باکتری، انتخاب تستهای تکمیلی و حتی تصمیمگیری درمانی را سریعتر و دقیقتر انجام دهند.
با وجود پیشرفتهای چشمگیر در روشهای مولکولی، همولیز استرپتوکوک ها روی بلاد آگار همچنان جایگاه آموزشی و عملی غیرقابل جایگزینی دارد و یکی از نخستین مهارتهایی است که دانشجویان علوم آزمایشگاهی میآموزند.






